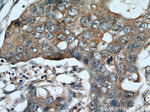
ADAM12 Antibody in Immunohistochemistry (Paraffin) (IHC (P))

Search
Proteintech
ADAM12 Polyclonal Antibody
{{$productOrderCtrl.translations['antibody.pdp.commerceCard.promotion.promotions']}}
{{$productOrderCtrl.translations['antibody.pdp.commerceCard.promotion.viewpromo']}}
{{$productOrderCtrl.translations['antibody.pdp.commerceCard.promotion.promocode']}}: {{promo.promoCode}} {{promo.promoTitle}} {{promo.promoDescription}}. {{$productOrderCtrl.translations['antibody.pdp.commerceCard.promotion.learnmore']}}
产品信息
14139-1-AP
种属反应
已发表种属
宿主/亚型
分类
类型
抗原
偶联物
形式
浓度
规格
纯化类型
保存液
内含物
保存条件
运输条件
产品详细信息
This antibody can recognize all isoforms of ADAM12. ADAM12 has 4 forms: 120 kDa full-length form, 90 kDa mature (processed form that lack the pro domain);50-68 kDa degradation product and 27 kDa pro domain.
Immunogen sequence: VSLWNQGRA DEVVSASVRS GDLWIPVKSF DSKNHPEVLN IRLQRESKEL IINLERNEGL IASSFTETHY LQDGTDVSLA RNYTGHCYYH GHVRGYSDSA VSLSTCSGLR GLIVFENESY VLEPMKSATN RYKLFPAKKL KSVRGSCGSH HNTPNLAAKN VFPPPSQTWA RRHKRETLKA TKYVELVIVA DNREFQRQGK DLEKVKQRLI EIANHVDKFY RPLNIRIVLV GVEVWNDMDK CSVSQDPFTS LHEFLDWRKM KLLPRKSHDN AQLVSGVYFQ GTTIGMAPIM SMCTADQSGG IVMDHSDNPL GAAVTLAHEL G (31-350 aa encoded by BC060804)
靶标信息
ADAM12 is a member of the ADAM (a disintegrin and metalloprotease-like domain) family. Two forms of ADAM12 have been described: ADAM12S and ADAM12L (short and long forms). The short form is a soluble form lacking the transmembrane and cytoplasmic domains. The short form of ADAM12 was reported to provoke myogenesis, and the lack of cytoplasmic domain suggests different regulation pathways (although both forms can be expressed in the same tissue).
仅用于科研。不用于诊断过程。未经明确授权不得转售。
生物信息学
蛋白别名: a disintegrin and metalloprotease domain 12; a disintegrin and metalloproteinase; a disintegrin and metalloproteinase domain 12 (meltrin alpha); ADAM; ADAM 12; ADAM 12-L; ADAM 12-S; ADAMs; Disintegrin and metalloproteinase domain-containing protein 12; meltrin alpha; Meltrin-alpha; metalloendopeptidases; metalloprotease-disintegrin 12 transmembrane; PRO545; RP11-295J3.5; unnamed protein product; UNQ346
基因别名: ADAM12; ADAM12-OT1; CAR10; MCMP; MCMPMltna; mKIAA4001; MLTN; MLTNA; UNQ346/PRO545
UniProt ID: (Human) O43184, (Mouse) Q61824
Entrez Gene ID: (Human) 8038, (Mouse) 11489